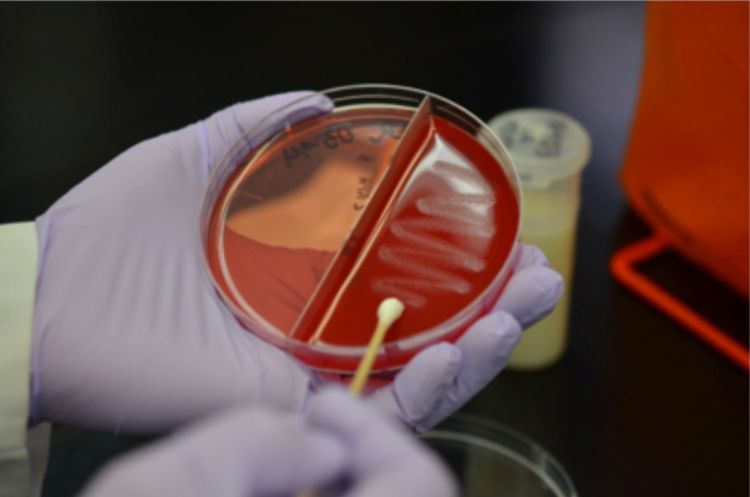

Advances in understanding Gram-positive mastitis on farms
Mastitis remains the most common and costly disease in the dairy industry, and most cases are treated with intramammary antibiotics.
Mastitis remains the most common and costly disease in the dairy industry, and most cases are treated with intramammary antibiotics. Mastitis is caused by a diverse group of pathogens, with about 25% of all mastitis cases caused by “Gram-positive” bacteria. For those who may not have taken microbiology recently, Gram-positive means that the cell wall of the bacteria is thicker and comprised primarily of a thick peptidoglycan cell wall. The cell wall is where many antibiotics attach to bacteria. Most antibiotics approved to treat mastitis are designed to be effective against Gram-positive bacteria.
There has been a lot of interest in different ways to reduce both antibiotic usage and the costs of treatment of non-severe cases of mastitis. Selective treatment for non-severe mastitis has been used for more than twenty years. It usually means that antibiotics are used to treat cases caused by Gram-positive bacteria but are not given to cases caused by Gram-negative bacteria or those that are culture negative when detected. In our recent study we compared the treatments used for Gram-positive cases of mastitis on commercial dairy farms.
Thanks to funding from the Michigan Alliance for Animal Agriculture (MAAA) we conducted a study to compare three intramammary treatments (3 days of PolyMast®, 3 days of Spectrmast LC®, 8 days of Spectramast LC®) to a negative control (animals that received no treatment).
Thanks to our supportive farm partners, research was conducted on three commercial farms in Michigan and one farm in Minnesota. After a cow experienced a non-severe case of clinical mastitis her milk was cultured. If the case was Gram-positive, the cow was randomly assigned to one of the three antibiotic treatments or a negative control. Two milk samples were collected at case detection. The first milk sample was collected for immediate on-farm culturing and somatic cell count. The second milk sample was frozen and cultured at a Michigan State University laboratory.
Despite all these cases being called “Gram-positive” on farm, there are actually a highly diverse group of pathogens (Figure 1). The effectiveness of approved antibiotics for many of these bacteria is either unknown or not well understood. This diversity of pathogens is likely why we did not see any differences between the rates of bacteriological cure between the treatments and negative control.

There were several cow-level risk factors that affected bacteriological cure. The probability of a case achieving bacteriological cure was much lower for older cows and cows with history of sub-clinical mastitis (high SCC) before the clinical case was detected. Based on this research we recommend that both the cow’s history and culture results should be reviewed before making a decision to use antibiotics.



 Print
Print Email
Email





